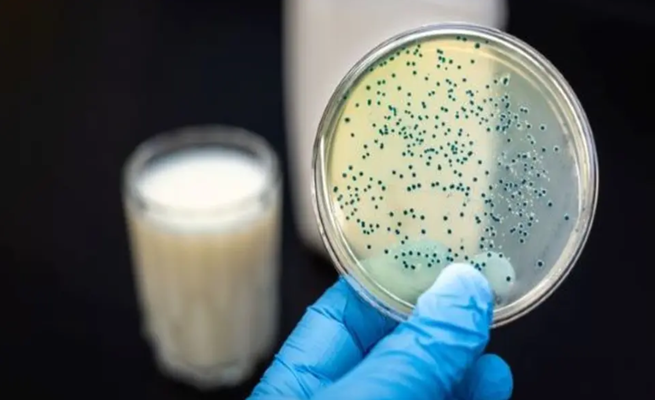

طفرة علمية مرتقبة في ألبان الرضاعة الصناعية
يعتبر حليب الأم خليطاً معقدا، ولا تزال بعض مكوناته لغزًا، حتى بالنسبة للعلماء الذين قضوا حياتهم المهنية في دراسته، بحسب ما نشرته صحيفة “وول ستريت جورنال”.
وبصرف النظر عن توفير التغذية، يوفر حليب الأم حماية للأطفال ضد الإسهال والحساسية والربو. ولكن وفقا لدراسة أجرتها مراكز مكافحة الأمراض والوقاية منها بالولايات المتحدة، تبين أن ثلث الآباء والأمهات الجدد يعتمدون على حليب الأطفال الصناعي وللغرابة أن بعضهم يختارون إرضاع أطفالهم حليبا صناعيا طوعا.
ولطالما حاول صناع حليب الأطفال التوصل إلى توليفة لمُنتج يمنح أكبر عدد ممكن من فوائد حليب الأم. ولكن، وفقاً لما قاله ريان كارفالهو، كبير المسؤولين الطبيين في إحدى الشركات العالمية لإنتاج الحليب وحليب الأطفال، لا يمكن لأي حليب أطفال صناعي أن يحل محل حليب الأم وربما تكمن الإجابة في نوع من السكر معقد كيميائياً يسمى أليغوساكاريدس، بمعنى الحليب البشري، والذي يشكل نحو ثلث المركبات الموجودة في حليب الأم.
وطبقاً لما ذكرت قناة “العربية” السعودية، يعتقد العلماء أن السكريات قد تكون مسؤولة عن العديد من الفوائد الصحية لرضيع حليب الأم فهي تغذي وتدعم بكتيريا الأمعاء الصحية، وتمنع البكتيريا المعدية، وتدعم تطوير أجهزة المناعة.
ووفقًا للأبحاث المختبرية والدراسات السريرية، تم التعرف على نحو 150عنصرا من الكائنات الحية المحورة HMO منذ الخمسينيات، ولكن الأمر استغرق حتى عام 2010 لإحدى الشركات الدنماركية لمعرفة كيفية الإنتاج الضخم لاثنين من تلك العناصر، معروفين باسم FL 2وLNnT.
وحقق الإنتاج الضخم انطلاقة لشركات الحليب الصناعي، التي تحاول تقليد حليب الأم بشكل أفضل، حيث جعل من الأسهل إجراء الأبحاث حول عناصر الكائنات الحية المحورة، وتوفير وسيلة فعالة من حيث التكلفة لإضافتها إلى تلك الصيغة.
ويعمل الباحثون حاليا على تحديد وصنع المزيد من الكائنات الحية المحورة على أمل زيادة تعزيز حليب الأطفال، وجعلها أقرب إلى حليب الأم. ووصف ستيفن تاونسيند، الكيميائي الذي يدرس الحليب البشري في جامعة فاندربيلت مساعي التطوير في صناعة حليب الأطفال بأنه “سباق تسلح لمعرفة عدد المركبات الصناعية، التي يمكنها التوصل إلها وتحويلها إلى منتجات”.
وتتطلع الشركة الدنماركية، التي تهتم بعناصر الكائنات الحية المحورة الموجودة بدرجات تركيز أعلى في حليب الأم، اعتماد إدارة الغذاء والدواء الأميركية بـ3 من عناصر الكائنات الحية المحورة في انتظار الاعتراف بسلامتها.
وبحسب ما ذكره آود هانسن، المدير التنفيذي للشركة الدنماركية، فإن هناك مجموعة أخرى من الكائنات الحية المحورة في طور التنمية في المختبر. وتتوقع الشركة، في السنوات الخمس المقبلة، إنتاج ما يتراوح بين 15 و25 من الكائنات الحية المحورة المختلفة، والتي تغطي حوالي 90 ٪ إلى 95 ٪ من HMO المتوافر بالفعل في حليب الأمهات.
ومن ناحية أخرى، قال لارس بودي الرئيس الموهوب لقسم الأبحاث في جامعة كاليفورنيا في سان دييغو، إن هناك أحد الكائنات الحية المحورة، التي يبدو أنها تقلل من خطر الإصابة بأمراض معوية تسمى التهاب الأمعاء والقولون الناخر عند الأطفال المبتسرين، مشيرا إلى أنه من المعروف أنه متوافر في حليب الأمهات لم التوصل إلى بديل له حتى الآن.
لقد وجدت تجربة الشركة الدنماركية لعام 2016، التي شملت أكثر من 400 رضيع، أن الذين تم إرضاعهم تركيبة تحتوي على 2FL لديهم مستويات منخفضة من البروتينات الالتهابية في دمهم، على غرار المستويات التي لوحظت عند الرضع الذين يرضعون طبيعيا. ووجدت دراسة أجرتها شركة أخرى عام 2017 على 175 رضيعًا أن أولئك الذين تناولوا تركيبة تحتوي على 2’FL وLNnT كانت معدلات الإصابة بالتهاب الشعب الهوائية واستخدام الأدوية أقل من الوالدين، بما في ذلك المضادات الحيوية، مقارنةً بالرضع الذين تناولوا تركيبة من غير عناصر الكائنات الحية المحورة.
هناك حاجة إلى مزيد من البحث لتحديد الفوائد السريرية بشكل حاسم لمعادلة عناصر الكائنات الحية المحورة، وفقًا لمراجعة عام 2018، التي تم نشرها في دورية Nutrients، بالإضافة إلى أن مسألة أخرى وهي أن حليب الأم يعتبر شخصيا للغاية، فلا يوجد شخصان لديهما نفس تكسير عناصر الكائنات الحية المحورة.
فعلى سبيل المثال، لا يتوافر FL.2 لدى حوالي ربع النساء، وبالتالي فإن أطفالهن لن يحصلوا عليها أبداً. وكما قال ميغان آزاد، عالم الأبحاث بمعهد أبحاث مستشفى الأطفال في معهد مانيتوبا التابع لليونيسف، والذي يدرس ميكروبيوم الرضيع: “إذا وضعناها في كل الصيغ، فكل طفل سيحصل عليها – ولا ندري ما إذا كانت جيدة أم سيئة”.
وقال دكتور تاونسيند إن الشركات المصنعة لهذه الصيغ من حليب الأطفال، التي تدمج عناصر الكائنات الحية المتحورة في منتجاتها، ينبغي عليهم المضي قدمًا بحذر، وبما يتماشى مع العلم.